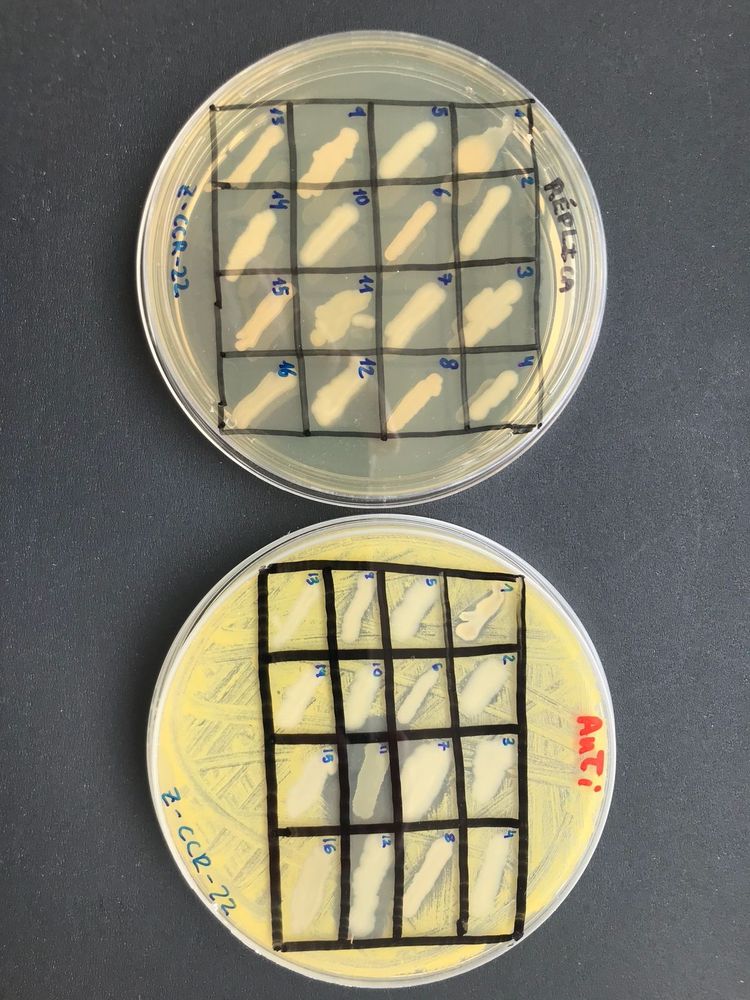

MicroMundo Unizar
@micromundouz.bsky.social
25 followers
4 following
170 posts
🌍 Nodo en Aragón del proyecto MicroMundo
🧫 Un proyecto de divulgación científica para descubrir nuevos antibióticos
🎓 @www.unizar.es
👇🏻👇🏻👇🏻
https://linktr.ee/micromundouz
Posts
Media
Videos
Starter Packs
Pinned